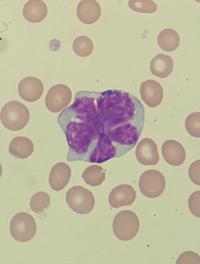
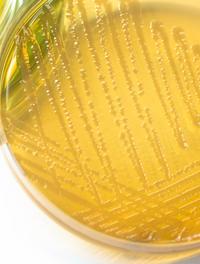

Quand P. falciparum fait de la résistance aux Tests de Diagnostic Rapide

Le paludisme reste aujourd’hui la première endémie parasitaire mondiale ; 94 % des cas sont observés en Afrique sub-saharienne, où [...]

Le paludisme reste aujourd’hui la première endémie parasitaire mondiale ; 94 % des cas sont observés en Afrique sub-saharienne, où [...]

Au vu du nombre de postes vacants dans les unités néonatales, la Société Française de néonatalogie (SFN) a lancé une évaluation de [...]
Le profil génétique et la biologie du myélome multiple (MM) sont hétérogènes et conduisent à des résultats cliniques variés. Les anomalies [...]

Les agonistes peptide glucagon-like 1 (GLP-1) sont autorisés dans le traitement du diabète et ont été, sans indication franche, employés [...]

Des images impressionnantes de crues dévastatrices nous parviennent de plus en plus souvent. L’augmentation des épisodes de très fortes [...]

Les programmes numériques de prise en charge à distance de l'hypertension artérielle (HTA) se multiplient. Selon l’analyse de cliniciens [...]

La bactériémie à Staphylococcus aureus n’est pas rare et souvent mortelle. Les options d’antibiotérapie sont limitées, en particulier [...]

L’intervalle entre 2 grossesses a été identifié comme un potentiel facteur de risque modifiable de complications périnatales et obstétricales [...]

Les cardiopathies congénitales sont les malformations les plus communes des nouveau-nés, les plus sévères nécessitent une intervention [...]

De récentes études ont suggéré que la psilocybine entrainait une réponse antidépressive rapide, dépassant, de loin, sa durée de présence [...]

Staphylococcus aureus est le pathogène le plus fréquemment en cause dans les infections de sites opératoires. La prévention et des [...]

L’occlusion percutanée de l'auricule gauche est une alternative aux anticoagulants pour prévenir les complications thromboemboliques [...]

Les lésions cérébrales post-traumatiques sont lourdes de conséquences dans toutes les tranches d’âge ; elles sont des causes majeures [...]

Chez les patients des unités de soins critiques (USC), l'hyperglycémie est fréquente et associée à un mauvais pronostic. Savoir si [...]

A la date de mai 2023, on comptabilisait aux Etats-Unis 1,1 million de morts par Covid-19. Il est alors apparu que les circonscriptions [...]

Le tabagisme fait partie des facteurs de risque les plus lourds de conséquences en termes de morbi-mortalité à l’échelle mondiale. [...]

L’isolement social et la solitude augmentent le risque de survenue de nombreuses pathologies, parmi lesquelles les pathologies cardio-vasculaires, [...]

L'obésité est une maladie hétérogène qui augmente le risque de mortalité toutes causes confondues. La chirurgie bariatrique, si elle [...]

La mucite bucco-pharyngée est une complication fréquente des traitements anti-cancéreux, qu’il s’agisse de la radiothérapie, de la [...]

Bien que souvent considérée comme secondaire par rapport à l’intervention elle-même, la cicatrice peut néanmoins revêtir une grande [...]

Malgré la fréquence relativement importante du trouble obsessionnel-compulsif (TOC) affectant environ 1,3 % de la population adulte, [...]

Une première fracture ostéoporotique augmente la probabilité d’une nouvelle fracture, notamment dans les deux années qui suivent l’évènement [...]

De nouvelles données indiquent que l’exposition à la pollution atmosphérique par les particules fines PM2.5, dont le diamètre est inférieur [...]

De nombreux types de régimes alimentaires ont été proposés pour perdre du poids ou éviter d’en prendre : pauvres en graisses pour certains, [...]
L’antibiothérapie continue au cours des reflux vésico-urétéraux a pour but de prévenir les infections urinaires (IU) et d’éviter les [...]

Le dépistage systématique du cancer du sein par mammographie est recommandé par les autorités de santé internationales. Il est associé [...]

Supplément de l’American Journal of Psychiatry destiné aux psychiatres en formation, le Residents’ Journal consacre un article à la [...]

La dermatomyosite (DM) est classée dans les myopathies inflammatoires. C’est une maladie rare avec une prévalence estimée entre 1/10 [...]

La charge anticholinergique d’un traitement se réfère à l’effet cumulé des médicaments à activité anticholinergique qui le composent. [...]

La peau est une barrière entre le milieu extérieur et notre corps ; c’est notre première ligne de défense contre les agressions extérieures [...]